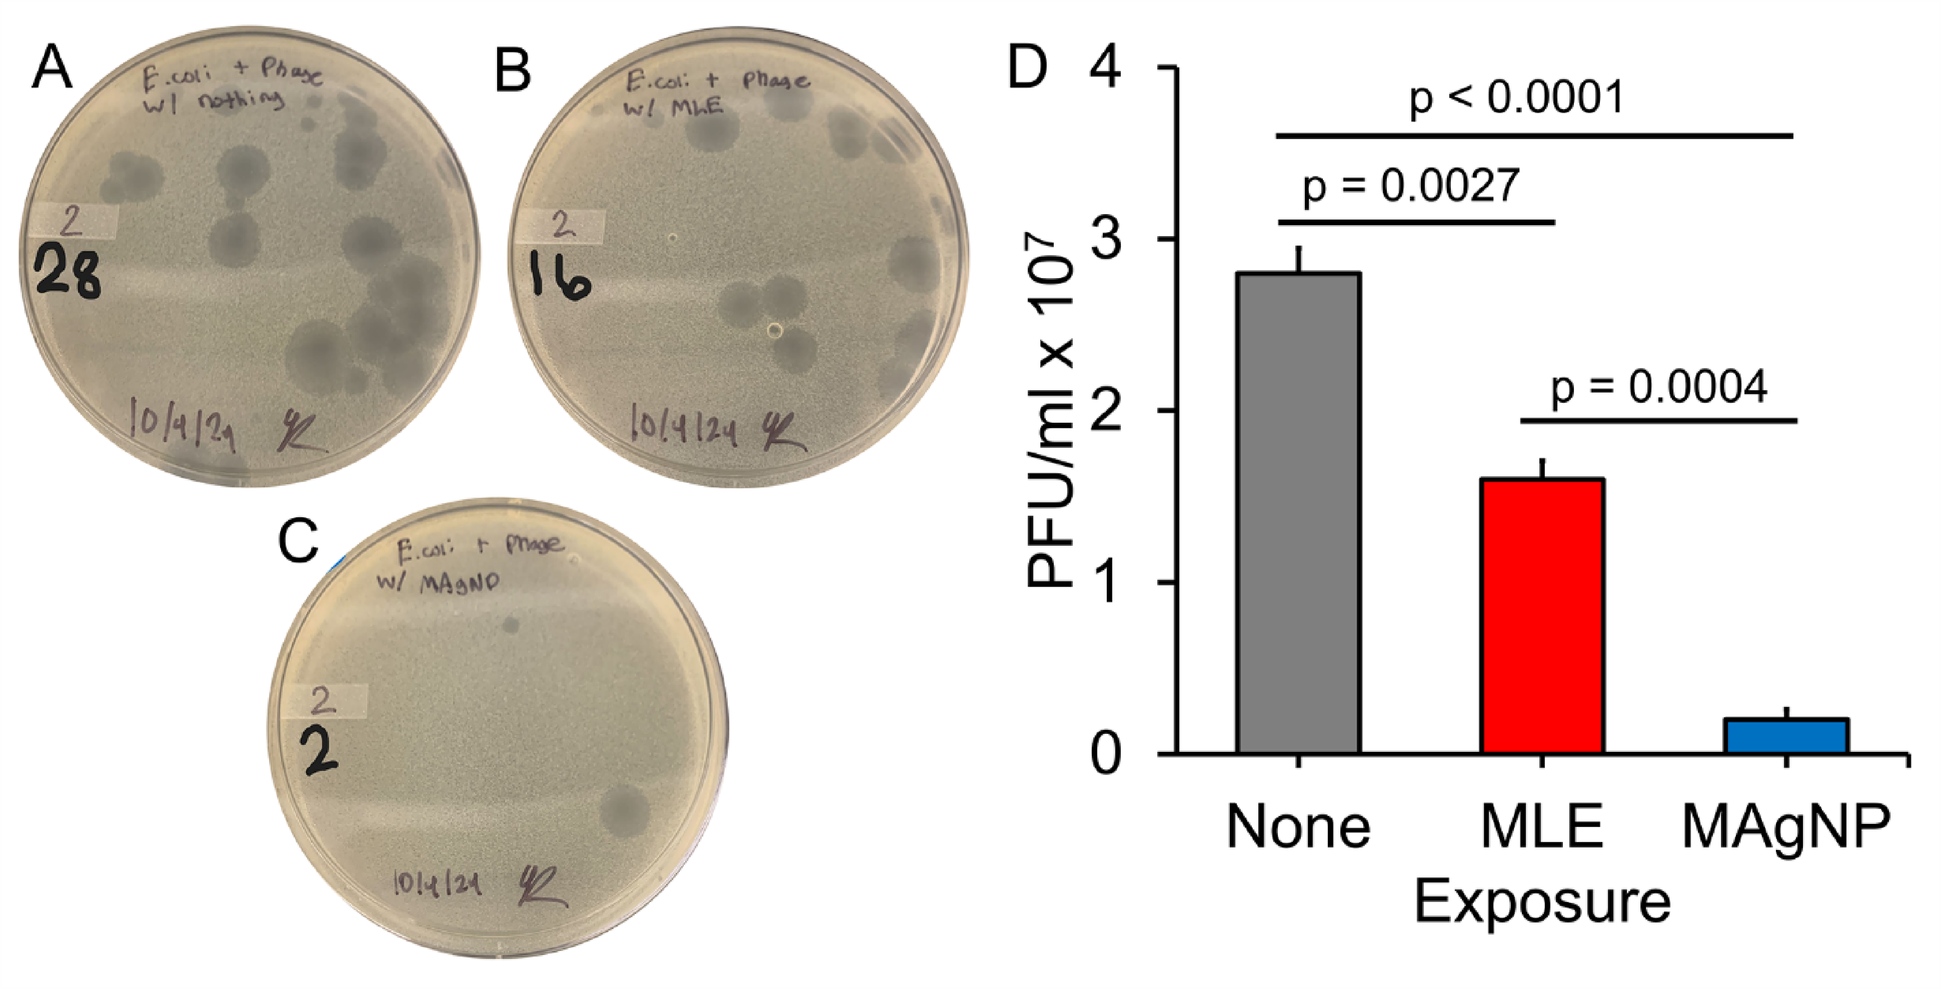
Fig. 5

Fig. 5
Bacteriophage plaque assay to examine the antiviral activity of Magnolia silver nanoparticles (MAgNPs). T7 coliphage (bacteriophage) exposed to different agents for 20 min and then incubated with E. coli BL21 strain for plaque formation. (A) No exposure, (B) Magnolia leaf extract (MLE), and (C) Magnolia silver nanoparticles (MAgNPs). (D) PFU/mL for each of the exposure groups after incubating at 37 °C overnight. This experiment was repeated at least 3 times, and a representative data set is shown. The error bars are the standard error of the mean (SE). P-values were obtained using a t-test to compare the means of the groups.